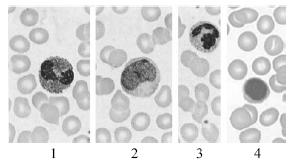
Enunciado 267817-1

Foram encontradas 2.896 questões.
Texto para as questões de 36 a 42
De acordo com dados epidemiológicos recentes, cerca de 8% da população brasileira entre 30 e 69 anos de idade é portadora de diabetes. Esse índice aumenta para 17% para os brasileiros com mais de 60 anos de idade. Como uma significativa proporção de diabéticos do tipo 2 é formada por assintomáticos ou oligossintomáticos, o diagnóstico da doença é, em geral, feito tardiamente. Assim, complicações macro e microvasculares estão freqüentemente presentes quando se detecta a hiperglicemia. Entre as alterações microvasculares, a retinopatia e a nefropatia constituem as principais causas de perda visual e de diálise. A neuropatia periférica e o comprometimento vascular periférico causado pela macroangiopatia e o surgimento de infecções favorecem o aparecimento de úlceras do chamado pé diabético.
Indivíduos diabéticos apresentam, em algumas situações, maior suscetibilidade a infecções. Por isso, são realizadas freqüentemente análises hematológicas para investigação dessas condições. Nas figuras acima, são mostradas células encontradas em diversos tipos de estudos hematológicos. Com base nessas informações e naquelas apresentadas no texto e considerando as análises hematológicas relacionadas às infecções, assinale a opção correta.
Provas
Texto para as questões de 36 a 42
De acordo com dados epidemiológicos recentes, cerca de 8% da população brasileira entre 30 e 69 anos de idade é portadora de diabetes. Esse índice aumenta para 17% para os brasileiros com mais de 60 anos de idade. Como uma significativa proporção de diabéticos do tipo 2 é formada por assintomáticos ou oligossintomáticos, o diagnóstico da doença é, em geral, feito tardiamente. Assim, complicações macro e microvasculares estão freqüentemente presentes quando se detecta a hiperglicemia. Entre as alterações microvasculares, a retinopatia e a nefropatia constituem as principais causas de perda visual e de diálise. A neuropatia periférica e o comprometimento vascular periférico causado pela macroangiopatia e o surgimento de infecções favorecem o aparecimento de úlceras do chamado pé diabético.
O teste oral de tolerância à glicose (TOTG) apresenta como vantagem a possibilidade de se realizar o diagnóstico de diabetes em suas fases mais precoces, quando o tratamento é mais eficaz. Ainda acerca do tema abordado no texto e acerca dos aspectos relacionados a esse teste, assinale a opção correta.
Provas
Texto para as questões de 36 a 42
De acordo com dados epidemiológicos recentes, cerca de 8% da população brasileira entre 30 e 69 anos de idade é portadora de diabetes. Esse índice aumenta para 17% para os brasileiros com mais de 60 anos de idade. Como uma significativa proporção de diabéticos do tipo 2 é formada por assintomáticos ou oligossintomáticos, o diagnóstico da doença é, em geral, feito tardiamente. Assim, complicações macro e microvasculares estão freqüentemente presentes quando se detecta a hiperglicemia. Entre as alterações microvasculares, a retinopatia e a nefropatia constituem as principais causas de perda visual e de diálise. A neuropatia periférica e o comprometimento vascular periférico causado pela macroangiopatia e o surgimento de infecções favorecem o aparecimento de úlceras do chamado pé diabético.
O principal teste laboratorial para o diagnóstico de diabetes é a dosagem de glicose. Com base no texto, assinale a opção correta a respeito dos diversos testes para dosagem desse carboidrato.
Provas
Texto para as questões de 36 a 42
De acordo com dados epidemiológicos recentes, cerca de 8% da população brasileira entre 30 e 69 anos de idade é portadora de diabetes. Esse índice aumenta para 17% para os brasileiros com mais de 60 anos de idade. Como uma significativa proporção de diabéticos do tipo 2 é formada por assintomáticos ou oligossintomáticos, o diagnóstico da doença é, em geral, feito tardiamente. Assim, complicações macro e microvasculares estão freqüentemente presentes quando se detecta a hiperglicemia. Entre as alterações microvasculares, a retinopatia e a nefropatia constituem as principais causas de perda visual e de diálise. A neuropatia periférica e o comprometimento vascular periférico causado pela macroangiopatia e o surgimento de infecções favorecem o aparecimento de úlceras do chamado pé diabético.
Diversos casos de diabetes do tipo 1 apresentam etiologia autoimune, em que células beta são alvo de ataque pelo sistema imune do próprio indivíduo. Também se observa, em alguns casos, a existência de anticorpos antiinsulina. Considerando os aspectos relacionados ao diabetes citados no texto, assinale a opção correta em relação às diversas provas de imunodiagnóstico.
Provas
Texto para as questões de 36 a 42
De acordo com dados epidemiológicos recentes, cerca de 8% da população brasileira entre 30 e 69 anos de idade é portadora de diabetes. Esse índice aumenta para 17% para os brasileiros com mais de 60 anos de idade. Como uma significativa proporção de diabéticos do tipo 2 é formada por assintomáticos ou oligossintomáticos, o diagnóstico da doença é, em geral, feito tardiamente. Assim, complicações macro e microvasculares estão freqüentemente presentes quando se detecta a hiperglicemia. Entre as alterações microvasculares, a retinopatia e a nefropatia constituem as principais causas de perda visual e de diálise. A neuropatia periférica e o comprometimento vascular periférico causado pela macroangiopatia e o surgimento de infecções favorecem o aparecimento de úlceras do chamado pé diabético.
Nos casos em que o diabetes está relacionado a alterações na capacidade de produzir insulina, pode ser necessário medir a dosagem desse hormônio. Considerando o texto e os métodos para dosagens hormonais, assinale a opção correta.
Provas
Texto para as questões de 31 a 35
Dengue é uma doença febril aguda, de etiologia viral e de evolução geralmente benigna na forma clássica e geralmente grave quando se apresenta na forma hemorrágica. A dengue é, hoje, a mais importante arbovirose (doença transmitida por artrópodes) que afeta o homem e é um sério problema de saúde pública no mundo, especialmente em países tropicais, onde as condições do meio ambiente favorecem o desenvolvimento e a proliferação do Aedes aegypti, principal vetor do vírus causador da doença.
A circulação simultânea de diferentes sorotipos do vírus da dengue no Brasil favorece a ocorrência de vários casos da forma hemorrágica da doença, que pode ser fatal em algumas situações. A forma hemorrágica pode desenvolver-se com alteração de permeabilidade vascular e coagulação intravascular com formação de trombos, seguida por hemorragias.Ainda acerca do tema tratado no texto, considere que, para a realização de prova de coagulação, seja necessário utilizar-se uma solução que contém 0,01 mol/L de CaCL2 e 0,9% (fração em massa) de NaCL. Considere-se ainda que M(NaCL) = 58,5 g/mol, M(CaCL2 ) = 111,0 g/mol e que as densidades de todas as soluções envolvidas seja de 1,0 g/mL. Dessa forma, para o correto preparo de 1 L da solução para prova de coagulação a partir de duas soluções distintas, uma contendo CaCL2 1 mol/L e outra, NaCL 300 mmol/L, é necessário que sejam utilizadas, respectivamente, as seguintes quantidades da solução de CaCL2 , da solução de NaCL e de água:
Provas
Texto para as questões de 31 a 35
Dengue é uma doença febril aguda, de etiologia viral e de evolução geralmente benigna na forma clássica e geralmente grave quando se apresenta na forma hemorrágica. A dengue é, hoje, a mais importante arbovirose (doença transmitida por artrópodes) que afeta o homem e é um sério problema de saúde pública no mundo, especialmente em países tropicais, onde as condições do meio ambiente favorecem o desenvolvimento e a proliferação do Aedes aegypti, principal vetor do vírus causador da doença.
A circulação simultânea de diferentes sorotipos do vírus da dengue no Brasil favorece a ocorrência de vários casos da forma hemorrágica da doença, que pode ser fatal em algumas situações. A forma hemorrágica pode desenvolver-se com alteração de permeabilidade vascular e coagulação intravascular com formação de trombos, seguida por hemorragias.A avaliação dos índices hematimétricos é de grande importância nas síndromes hemorrágicas em geral, inclusive na causada por dengue. Com base no texto e acerca desses índices, assinale a opção correta.
Provas
Texto para as questões de 31 a 35
Dengue é uma doença febril aguda, de etiologia viral e de evolução geralmente benigna na forma clássica e geralmente grave quando se apresenta na forma hemorrágica. A dengue é, hoje, a mais importante arbovirose (doença transmitida por artrópodes) que afeta o homem e é um sério problema de saúde pública no mundo, especialmente em países tropicais, onde as condições do meio ambiente favorecem o desenvolvimento e a proliferação do Aedes aegypti, principal vetor do vírus causador da doença.
A circulação simultânea de diferentes sorotipos do vírus da dengue no Brasil favorece a ocorrência de vários casos da forma hemorrágica da doença, que pode ser fatal em algumas situações. A forma hemorrágica pode desenvolver-se com alteração de permeabilidade vascular e coagulação intravascular com formação de trombos, seguida por hemorragias.Tendo o texto como referência, assinale a opção correta quanto às diversas análises laboratoriais relacionadas à coagulação.
Provas
Texto para as questões de 31 a 35
Dengue é uma doença febril aguda, de etiologia viral e de evolução geralmente benigna na forma clássica e geralmente grave quando se apresenta na forma hemorrágica. A dengue é, hoje, a mais importante arbovirose (doença transmitida por artrópodes) que afeta o homem e é um sério problema de saúde pública no mundo, especialmente em países tropicais, onde as condições do meio ambiente favorecem o desenvolvimento e a proliferação do Aedes aegypti, principal vetor do vírus causador da doença.
A circulação simultânea de diferentes sorotipos do vírus da dengue no Brasil favorece a ocorrência de vários casos da forma hemorrágica da doença, que pode ser fatal em algumas situações. A forma hemorrágica pode desenvolver-se com alteração de permeabilidade vascular e coagulação intravascular com formação de trombos, seguida por hemorragias.Considerando o texto e os diversos aspectos do diagnóstico laboratorial das infecções virais, assinale a opção correta.
Provas
- Biologia Celular
- Meio AmbienteDoenças urbanas
- Metodologia CientíficaPráticas Laboratoriais
- Virologia
Texto para as questões de 31 a 35
Dengue é uma doença febril aguda, de etiologia viral e de evolução geralmente benigna na forma clássica e geralmente grave quando se apresenta na forma hemorrágica. A dengue é, hoje, a mais importante arbovirose (doença transmitida por artrópodes) que afeta o homem e é um sério problema de saúde pública no mundo, especialmente em países tropicais, onde as condições do meio ambiente favorecem o desenvolvimento e a proliferação do Aedes aegypti, principal vetor do vírus causador da doença.
A circulação simultânea de diferentes sorotipos do vírus da dengue no Brasil favorece a ocorrência de vários casos da forma hemorrágica da doença, que pode ser fatal em algumas situações. A forma hemorrágica pode desenvolver-se com alteração de permeabilidade vascular e coagulação intravascular com formação de trombos, seguida por hemorragias.
Na figura acima, está ilustrado o vírus da dengue, um arbovírus ssRNA do gênero Flavivirus. Considerando essa figura e as informações do texto, assinale a opção correta.
Provas
Caderno Container